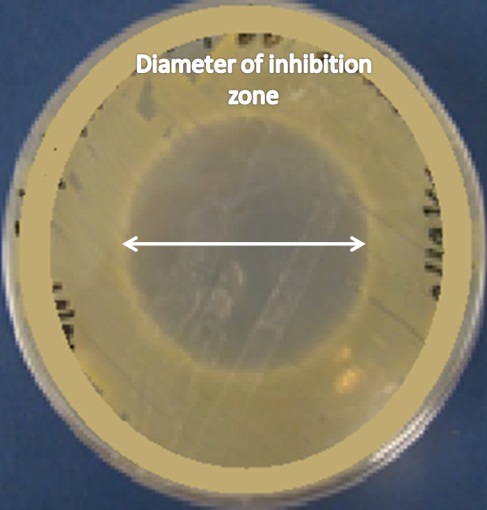

1*Ministry of Health, Baghdad, Iraq, 1*Pharmaceutics Department, College of Pharmacy, University of Baghdad, Baghdad, Iraq.
Email: senior.pharmacist.issam@gmail.com
Received: 24 Sep 2014 Revised and Accepted: 22 Oct 2014
ABSTRACT
Objective: Lyophilized nasal insert formulations containing 2% mupirocin which is an antibiotic used to prevent serious infections caused by meticillin resistant Staphylococcus aureus (MRSA) pathogen were prepared.
Methods: Different grades of methylcellulose (MC) polymer were used to prepare mupirocin nasal inserts using aqueous (water) and organic (tertiary butyl alcohol) methods. Dynamic adhesion, drug release profile and antibiotic sensitivity studies were undertaken to evaluate the performance of the nasal inserts in comparison to Bactroban nasal ointment.
Results: The results showed that each grade of MC polymer has different adhesion properties. In organic prepared formulations, the solution form of mupirocin in tertiary butyl alcohol resulted in a significant increase in the adhesion of these formulations in comparison with blank formulations. On the other hand, mupirocin suspended in aqueous solvent (water) had little effect. However both aqueous and organic prepared formulations resulted higher adhesion performance when compared to Bactroban nasal ointment. The drug release of incorporated mupirocin from MC matrix of organic prepared formulations after 180 minutes was slower (11.9-12.5%) than mupirocin from aqueous prepared formulations (85.6-88.4%). while, the maximum percent of mupirocin released from Bactroban nasal ointment was just 4% after the same time.
Conclusion: The growth inhibition of Staphylococcus aureus pathogen obtained by using lyophilized nasal insert formulation which contained Mupirocin was very active. Thus, the nasal insert is promising in treatment of nasal colonized by MRSA.
Keywords: MRSA, Nasal inserts, Nasal dosage form, Lyophilization, Bioadhesion, Mupirocin, Methylcellulose.
INTRODUCTION
The nose is primarily considered for local administration of pharmaceutical agents, for example decongestants, antihistamines and some local antibiotics to treat some nasal infections [1]. The nasal mucosa also has the ability to achieve direct absorption to the systemic circulation, since it is a thin epithelial layer and there are a large number of blood vessels. The anatomical, physiological and histological characteristics of the nasal cavity provide the possibility of both local and systemic drug treatment [2].
The meticillin resistant Staphylococcus aureus (MRSA) is a species of bacterium commonly found on the skin and/or in the noses of healthy people. Approximately 1/3 of healthy people carry this type of infectious bacteria. Although it is usually harmless at these sites, it may infrequently get into the body through breaks in the skin such as; abrasions, cuts, wounds, surgical incisions or indwelling catheters that may cause infections. These infections could be mild such as pimples or boils, or may cause more serious infections of the blood stream, bones or joints. The infections caused by MRSA are called nosocomial infections when they transfer from one patient to another, hospital staff, contaminated objects, solutions or from the patient himself (transfer from one site of the body to another) in the hospitals or healthcare units [3].
Many literature evaluated the use of Mupirocin antibiotic to eliminate carriage and reduce the risk of the bacteria spreading either to other sites on the patient's body or to other people, where they might cause surgical site infections (SSIs) [4,5]. This topical antibiotic inhibits bacterial isoleucyl tRNA synthetase, blocking the formation of isoleucyl tRNA, which in turn impairs bacterial protein synthesis [3,6]. The dosage forms of mupirocin used in these literatures either as nasal solution [4,5] or ointment[7,8]. The main drawback of nasal route is the mucociliary clearance () that clears the dosage form within 21 minute [9]. Therefore, application of mupirocin nasal ointment could be ineffective or relapses may happen. The presence of a bioadhesive polymer in nasal formulation is essential that may improve the bioavailability of the drug, since this material will increase the residence time of the formulation within the nasal cavity and overcome . Consequently, this increases the chance of the drug to exert its effect locally or for systemic effect[10].
One of the novel nasal dosage forms under investigation is the nasal insert prepared using lyophilization or freeze drying technique [11, 12]. There are many advantages in using this technique, including enhanced stability and shelf life. McInnes and co-workers reported the preparation of lyophilized hydroxypropyl methylcellulose (HPMC) nasal insert [13], to be handled and administered to the nasal cavity manually. As the insert contacts the moist surface of the nose such as the nasal mucosa, it hydrates and forms a gel of a higher concentration of HPMC than originally prepared prior the lyophilization. It is proposed that this re-hydrated, concentrated HPMC gel could result in increased bio adhesion and therefore residence time in the nasal cavity, in combination with enhancement of absorption due to a transient dehydrating effect on the nasal mucosa.
So the aim of this work is the preparation of mupirocin nasal insert by lyophilization using bioadhesive or mucoadhesive polymers such methyl cellulose (MC) to decrease the rate of MCC and increase the residence time of nasal dosageforms. The fast and prolonged onset of action of antibiotic as mupirocin can be achieved to treat the nasal colonization of MRSA.
MATERIALS AND METHODS
Mupirocin pure USP was bought from Appli Chem, Darmstadt, Germany. Bactroban nasal ointment (2% w/w mupirocin) was purchased from GlaxoSmithKline, UK. Methylcellulose (MC) powders; A4M Prem and A15C Prem were gifts from Dow Chemicals Ltd, Michigan, USA. Potassium chloride was purchased from Fisher scientific, Leicestershire, UK. Sodium chloride ≥ 95.5% purification and porcine stomach mucin type II were obtained from Sigma-Aldrich, Dorset, UK. Calcium chloride, sodium dodecyl sulphate and tertiary butyl alcohol were obtained from Sigma-Aldrich, Germany. The ultra-pure agar and Parafilm® were purchased from VWR, Poole, UK. Distilled water was produced in house.
Methods
of blank MC gels
The formulations prepared by the following method were organized as outlined in Table1. The blank gels of 1% MCA4M and 1% MCA15C (formulations 1-2 respectively) were prepared by weighing out about 10 g of distilled water into suitable containers, adding the suitable mass of MC polymer powder (grade; A4M or A15C) to get the required concentration (1%) of each grade. The MC polymer was dissolved by stirring thoroughly using a glass rod. The 20 g final weight of each formulation was completed by adding more distilled water, and the gel was left overnight with continuous stirring to allow complete hydration. The formulations were stored overnight in the fridge at 4 °C before use to allow air bubbles to dissipate.
Table 1: The prepared formulations
| Formulation | MCA4M (% w/w) | MCA15C (% w/w) | Tertiary butyl alcohol (% v/v) | Mupirocin (% w/w) |
| 1 | 1 | - | - | - |
| 2 | - | 1 | - | - |
| 3 | 1 | - | - | 2 |
| 4 | - | 1 | - | 2 |
| 5 | 1 | - | 20 | 2 |
| 6 | - | 1 | 20 | 2 |
Mupirocin containing MC gels
The mupirocin powder is very slightly soluble with water, and soluble in tertiary butyl alcohol, so two methods were employed in preparing MC gels containing 2% mupirocin.
Mupirocin aqueous formulations
The suspension forms (formulations 3 and 4, table 1) were prepared by weighing out about 10 g of distilled water in the suitable containers. The correct weight of mupirocin powder was added and stirred. Weighed amounts of MC (grade A4M or A15C) polymer powders were added and stirred thoroughly in the same procedure as described in blank gel preparation to obtain well suspended particles of mupirocin in uniform MC gels.
Mupirocin organic formulations
Formulations 5 and 6 in table 1 were prepared by adding the required volume of tertiary butyl alcohol (20% v/v solution) to dissolve the appropriate mass of mupirocin. The required mass of MC polymer(grade A4M or A15C) powders was added to the one third of the final mass of 20% v/v tertiary butyl alcohol. The mixture was stirred until a uniform gel was obtained, following by addition the remaining 20% v/v tertiary butyl alcohol. The resultant gels were stored at 4°C overnight to allow complete hydration and to remove air.
Preparation of nasal inserts and discs
The nasal inserts were prepared by measuring 0.3 ml volume of blank formulations 1 and 2, and mupirocin aqueous formulations 3 and 4 (Table 1), in micro centrifuge tubes and lyophilized them using a Virtis advantage freeze drier (EPSILON 2-4 LSC, New York, USA).
A Christ freeze dryer supplied by EPSILON 2-4 LSC, New York, USA was used in the preparation of nasal inserts containing mupirocin organic formulations 5 and 6, table 1. In order to stop a potentially hazardous increase of solvent vapor, Christ freeze dryer with specific system configuration was used to achieve a lower temperature. Both dryers of this company involve detailed information to create validation documents (IQ/OQ documentation) and to prepare monitoring tools that ensure flawless product quality. They do not only use standard measurements of product temperature and pressure, but also measurements of electrical resistance and weight-change (weighing cell) during the drying process. Optimal product safety can thus be guaranteed. Unacceptable structural changes including the collapse of the matrix can be avoided with confidence[14].
The disc shaped lyophilizates were used for the evaluation tests as dynamic adhesion and zone of inhibition, to reduce variation caused by the torpedo shape of the insert. This was achieved by filling plastic molds with 0.3 ml of gel formulations 1-6, table 1 then lyophilized using freeze dryer.
Preparation of simulated nasal solution (SNS)
The simulated nasal solution (SNS) was prepared to mimic the nose conditions. Shah and co-authors reported a simulated nasal solution which contained calcium chloride, potassium chloride and sodium chloride and the pH of this solution was adjusted to 5.5[15]. This solution was prepared by dissolving 2.95g calcium chloride (CaCl2.2H2O), 14.9g potassium chloride (KCl) and 43.85g sodium chloride (NaCl) in a glass beaker containing about 1000 ml of stirred distilled water. The completely clear solution was then transferred to a 5000 ml volumetric flask and made up to the final volume with more distilled water.
In-vitro dynamic adhesion
In order to examine the mucoadhesive potential of the MC formulations in table 1 and Bactroban nasal ointment, an artificial nasal mucosa was prepared according to methods described elsewhere [16,17]. The required weight of agar powder was weighed out and dissolved in boiling distilled water to obtain a 1% w/v concentration of clear agar solution, following which the agar solution was removed from the hot plate and left to cool down to 50 °C. The appropriate weight of mucin powder was weighed out and sprinkled in a glass beaker which contained distilled water, stirred using a magnetic stirrer to obtain a 2% w/v of mucin suspension. The mucin suspension was added to the warm agar solution and stirred, and then the mixture quickly was poured into 25 cm x 25 cm plastic plates purchased from VRW International Ltd., Poole, UK, and then left on the bench for 30 minutes to cool. The plates were wrapped in cling film to prevent water loss and stored overnight in the fridge at 4 °C in order to be used to measure the dynamic adhesion for nasal insert dosage form.
Dynamic vapor sorption (DVS)
The dynamic vapor sorption test (Surface Measurement System, SMS Ltd., Alperton, UK) was carried out for MC containing mupirocin; aqueous formulations 3 and 4 and organic formulations 5 and 6 to determine how the formulations might react when exposed to the same humidity of the nasal cavity. DVS was used to produce controlled conditions in which the temperature and humidity surrounding the sample can be regulated. Samples weighing 10 mg were loaded on to the pan and the program was set to control the humidity at 0% RH, followed by increasing RH in 10% increments to 95%. The RH was then decreased through the same steps, and the temperature maintained at 25 ±0.5°C throughout the cycle A sorption/desorption profile was obtained from the DVS software (Surface Measurement System, SMS Ltd., Alperton, UK), and the overall mass increase of the sample (in relation to the dry weight) at 95% RH was calculated to assess the extent of water vapor sorption.
Scanning electron microscope images (SEM)
The SEM images were obtained for formulations 1, 2, 4 and 6, table 1 to study the matrix of the nasal inserts of two MC grades A4M and A15C and in the presence of drug model (mupirocin) and the effect of using two different processing techniques on the final matrix. The samples were prepared by cutting the selected nasal insert formulations longitudinally and gluing them on 10 mm aluminum stubs using double sided copper tape. These samples were coated with a gold layer using a sputter coating system (Polaron SC 515, Ashford, UK). Observations were made with a JEOL 6400 SEM operating at 6KV using the secondary electron mode.
Differential scanning calorimetry (DSC)
DSC (DSC822e Model; TA controller TC15, Mettler-Toledo Ltd., Leicester, UK) and its software (Stare system, Mettler-Toledo Ltd., Leicester, UK) were used to study the effect of organic and aqueous preparation methods on the physical properties of mupirocin in formulations 3, 4 and 5, 6 (aqueous and organic prepared formulations respectively, table 1).
A heating rate of 10 °C per minute was used to heat the sample from 15-240 °C, to study the physical properties of processed formulations in comparison to the components.
Nuclear magnetic resonance (NMR)
1H-NMR (Delta V 4.3.3, ECX-400MHz, Jeol, Tokyo, Japan) was used to elucidate any chemical shift and residual amount of tertiary butyl alcohol in formulations 5 and 6 in comparison to aqueous prepared formulations 3 and 4. Weights of 20 mg were taken from selected lyophilized nasal inserts (aqueous formulation 5 and organic formulation 6) in table 1, and dissolved using 1.5 ml of deuterium oxide (D2O) and left overnight or longer to complete the dissolution process. The obtained solutions were transferred to glass tubes (NMR tubes) for analysis.
Mupirocin release study
The dissolution medium of mupirocin containing nasal inserts (formulations 3-6, table 1)was a simulated nasal solution containing 2% sodium lauryl sulphate (SLS) as a surfactant to provide sink conditions for poorly water soluble mupirocin[18]. SLS was dissolved in the SNS, and that it was warmed to prevent precipitation of SLS and then stored at 37 °C.
The drug dissolution profiles for mupirocin from the nasal insert formulations and Bactroban nasal ointment were determined using water jacketed Franz cells (Franz cells and system, Perme Gear, Hellertown, USA). Each cell was composed of; donor compartment, cellulose nitrate membrane, sampling port, heater/circulator, receptor compartment (filled with SNS as dissolution medium) water jacket and small magnetic stirrer.
The receptor capacity of each cell was 20 ml volume. The 5 mm cellulose nitrate membranes (Whatman, VRW, Leicestershire, UK) were held on the top of the cells just in contact with the receptor medium, and the inserts were placed on top of the membrane in order to allow the inserts to be hydrated and to subsequently release drug. The top of the cell was sealed using paraffin film (VRW International Ltd., Poole, UK) to prevent evaporation of the receptor media. The experiment was designed in this way to simulate nasal medium.
Different concentrations of mupirocin solution were prepared using warm SNS containing 2% w/v SLS (the media to be used as a receptor medium in the mupirocin release test)[18,19]. The prepared solutions were scanned to obtain the λ max of the mupirocin. A volume of 0.5 ml was withdrawn from the receptor compartment at regular time intervals (every 15 minutes for the first hour and every 30 minutes for a further 6 hours) and instantly replaced with fresh simulated nasal solution, SNS.
Antibiotic sensitivity test
The antibiotic sensitivity test (zone of growth inhibition) was performed to assess the ability of MC nasal formulations containing mupirocin (3-6) to diffuse mupirocin from the formulation and inhibit the growth of Staphylococcus aureus. This study was achieved in comparison to Bactroban nasal ointment as control (n=3). A Staphylococcus aureus suspension was incubated on the surface of nutrient agar which was poured into plastic petri dishes. The selected disc formulations and the prescribed dose of Bactroban nasal ointment (control) were located in the centre of these dishes using flamed and cooled forceps. All these plates were incubated at 37 °C overnight and the diameter of inhibition of bacterial growth around the hydrated gel was measured using a digital calliper.
Statistical analysis
A T-test was used for two samples of equal variances, to analyze the significant differences among formulations by changing one factor. This test was used for all analytical studies in this work. The differences were considered significant when the probability was P ≤ 0.05.
The similarity factor (f2, Equation 1) was used to analyze the degree of similarity of the release profiles of MH formulations using the following Equations. The dissimilarity was significant when f2< 50[20, 21].
Equation 1
RESULTS AND DISCUSSION
General observation of MC gels, inserts and discs
The blank formulations which contained MCA4M and MCA15C (formulations 1-2 respectively) had the same appearance which was clear and transparent since these are water soluble polymers[22]. Formulation 2 (MCA15C) was less viscous solution in comparison to formulation 1 (MCA4M).
The appearance of mupirocin containing gel formulations 3 and 4 were white suspensions, the particles were suspended homogenously because the methyl cellulose is one of good suspending and thickening agents [22].
It was difficult to dissolve mupirocin powder since it is only slightly soluble in distilled water. Adding the required volume to obtain 20% of the tertiary butyl alcohol in the final gel increased the solubility of the mupirocin. The appearance of these mupirocin solution containing gels, formulations 5 and 6was different in comparison to mupirocin suspension containing gels, formulations 3 and 4. The mupirocin solution containing gel formulations 5 and 6 were more viscous than mupirocin suspension containing gel formulations 3 and 4 respectively which contained the same components but water was used to suspend the mupirocin particles in the latter formulations.
All blank MC lyophilized nasal insert and disc formulations 1 and 2 had the same white conical appearance for inserts and regular circular shape for discs, and were spongy and springy in texture. The size of these inserts was approximately 1.7 cm in length while the discs were 10 mm in diameter and 3.5 mm in height.
The mupirocin suspension containing MC lyophilized nasal insert or discs formulations 3 and 4 were denser, harder and whiter than for equivalent blank formulations (1 and 2 respectively) due to the presence of suspended mupirocin particles.
The mupirocin solution containing MC lyophilized nasal insert or discs formulations 5 and 6 were different in comparison to formulations 3 and 4 which contained the same components but, water was used to suspend the mupirocin particles. These inserts and discs were very soft and stuck to the walls of their molds, so it was difficult to remove them to perform the required experiments. This may result from the solvent that was not being sufficiently removed and caused over plasticized formulations. This suggestion required further chemical study using NMR to determine any residual of solvents in those formulations.
In-vitro dynamic adhesion
The discs of tested formulations travelled down the mucin/agar surface at different rates depending on the ability of these formulations to absorb water from the media and interact with the test surface. If the distance travelled was short, that means the disc had high adhesion and vice versa.
In case of using different grades of MC polymer (A4M and A15C) at the same concentration (e. g. 1%), there were significant differences (P≤0.05) in the adhesion of the lyophilized discs as shown in Figure1. The adhesion of MCA15C was lower than MCA4M, maybe due to its low molecular weight (63000 Dalton) in comparison to MCA4M (86000 Dalton)[23]. This suggests that, the low molecular weight polymer produced less swelling and less entanglement of polymer chains within the glycoprotein of the mucin as a result of the linear structure of the polymer [10, 24].
In case of addition of mupirocin in suspension form as aqueous formulations 3 and 4 resulted in a significant decrease (P≤ 0.05) in the adhesion of these formulations as shown in Fig. 1. The drug used in these formulations (mupirocin) is hydrophobic, suggesting that the presence of mupirocin may lead to a decrease in the hydration or water uptake of the formulation matrix and its swelling. Consequently, the ability of the chain sections of the polymer to interact and become entangled with the glycoprotein of the mucin was restricted[24], with a resultant decrease in the dynamic adhesion of these formulations.

Fig. 1: Dynamic adhesion of MC formulations and Bactroban ointment, n=6
The addition of mupirocin dissolved using 20% tertiary butyl alcohol as organic formulations 5 and 6, resulted in a significant (P ≤ 0.05) increase in their dynamic adhesion to mucin-agar plates in comparison to aqueous prepared formulations 3 and 4 as shown in Fig. 1. In addition, Fig. 1 shows that a significant increase in the adhesion of these organic formulations was resulted when compared to the MC blank formulations 1 and 2respectively. The large differences in the dynamic adhesion of mupirocin solution containing MC lyophilized discs formulations 5 and 6 in comparison to suspension formulations 3 and 4 respectively might result from higher water uptake due to physical or chemical changes which may have occurred within the matrix, as the same quantity of hydrophobic drug was used in each formulation. Therefore, further studies such as water uptake measurement using the DVS; scanning electron microscope images (SEM) and nuclear magnetic resonance (NMR) are required to understand these behaviors.
On the other hand, it was found that In vitro dynamic adhesion of the prescribed dose of Bactroban nasal ointment which had approximately the same weight of one lyophilized disc was very low, as shown in Figure1. The tested quantity of Bactroban nasal ointment travelled and reached the bottom of the agar plate within 15 minutes compared to 270 minutes or more for the lyophilized mupirocin/polymer formulations 1-6. This suggests that the Bactroban nasal ointment may not remain long enough in the nose to produce its full effect, due to mucociliary clearance. Within the first 5 minutes, it travelled far enough to have been cleared from the nose. The observed low adhesion of Bactroban is one of the main disadvantages of ointments, in which their low water holding capacity is a very important factor for adhesion [25].
Dynamic vapor sorption (DVS)
The water sorption by lyophilized nasal inserts of blank formulation 2, formulations 3 and 4 (aqueous prepared inserts) and organic prepared inserts 5 and 6 was measured as illustrated in table 2.
Table 2: Percent of water sorption of blank MC nasal inserts and mupirocin containing inserts
| Formulation | % Water sorption (at 95% RH) |
| Formulation 2, MCA15C | 42.35 |
| Formulation 3, MCA4M+mupirocin, Aqueous | 9.763 |
| Formulation 4, MCA15C+mupirocin, Aqueous | 11.44 |
| Formulation 5, MCA4M+mupirocin, Organic | 14.30 |
| Formulation 6, MCA15C+mupirocin, Organic | 15.94 |
The formulation 4 gave lowest water sorption in comparison to blank formulation 2, suggesting that addition of hydrophobic drug, mupirocin, resulted in a decrease in water uptake of this formulation 4. These results can confirm the results obtained from the adhesion test which was performed using the mucin-agar plate method. The dynamic adhesion of aqueous prepared formulations (3 and 4) was lower than the blank formulations (1 and 2)[26].
In case of addition of 20% tertiary butyl alcohol to dissolve the mupirocin powder as in formulations 5 and 6 led to an increase in the water sorption in comparison with formulations 3 and 4 respectively as shown in table 2. The increase in the humidity absorption by formulations containing mupirocin in solution form (organic prepared formulations) in comparison to formulations containing mupirocin in suspension form (aqueous prepared formulations) maybe due to a change in the polymer matrix structure resulting from the effect of preparation techniques.
As the presence of tertiary butyl alcohol to dissolve the mupirocin powder in formulations 5 and 6 resulted in solution form of drug in organic solvent, instead of hydrophobic effect of mupirocin when it was in suspension form in water in formulations 3 and 4. Correlating these results with dynamic adhesion results show the significant increase observed in the adhesion of mupirocin solution containing formulations 5 and 6 could have been due to the increase in thewater uptake of these formulations in comparison to the blank or mupirocin suspension containing formulations 3 and 4 [26].
Further studies were required such as scanning electron microscope images to understand the effect of drug addition (in an aqueous or organic form) on the resulted matrix and its effect on the dynamic adhesion. Also, nuclear magnetic resonance was important to determine any residual of organic solvent (tertiary butyl alcohol) that might increase the water uptake and adhesion of organic prepared formulations 5 and 6.
Scanning electron microscope (SEM)
The images were obtained for blank formulations 1 (MCA4M) and 2 (MCA15C) as shown in Figures 2a and 2b. A clear view about the difference in the micro-structure of the nasal inserts prepared using the same concentration and different grades of MC polymer, was observed. The formulation 1 (Fig. 2a) appears denser and has smaller and less numerous pores in comparison to the formulations 2(Fig. 2b). These results can confirm the results obtained from dynamic adhesion experiment, adhesion of MCA4M was higher than MCA15C due to its highest molecular weight and viscosity so, it was the densest structure.
In case of addition of mupirocin (crystal form, Fig. 2c) which is a hydrophobic drug in suspension form inthe aqueous prepared formulation 4 (MCA4M+ mupirocin suspension), produced a uniform distribution of these crystals within the wings structure of the lyophilized polymers as shown in Fig. 2d with magnification 200 µm and 20 µm.
The Fig. 2e with magnification 200 µm and with 20 µm shows that organic prepared formulation 6, which contained MCA15C and mupirocin in solution form, resulted in an amorphous form of the drug being visible after lyophilization in comparison to the blank formulation (Fig. 2b). The structure of the polymer (wings) also looks different in comparison to the mupirocin suspension containing formulations (Fig. 2d) in which the matrix of this formulation 6 was a sheet like in structure. These changes might result from the effect of solvent used in the preparation of those formulations that modified the matrix morphology after evaporation through freeze drying technique. This suggests that it may be the altered matrix morphology which caused an increase in the water uptake of formulations 5 and 6 which was observed with DVS results in table 2. Elgindy and co-authors found that lyophilization of hydrophobic drug using water/tertiary butyl alcohol mono-phase solution with hydrophilic polymer such as MC (A4M, A15C or A15LV) created an amorphous drug-polymer complex[27]. Therefore, new physical properties would result, such as water uptake[28], so differential scanning calorimetry was required to confirm the amorphous formation of the drug.

a. Formulation 1 (blank MCA4M) b. Formulation 2 (blank MCA15C)

c. Mupirocin powder

d. Formulation 4 (MCA15C+ mupirocin aqueous suspension)

e. Formulation 6 (MCA15C+ mupirocin organic solution)
Fig. 2: SEM images of MC formulations with and without mupirocin
Differential scanning calorimetry (DSC)
As shown in Fig. 3, mupirocin has an endothermic peak of its melting point at 78.15°C which was also observed in the aqueous prepared formulation 4. The thermogram of formulation 2 (blank MCA15C)has an endothermic peak of dehydration between 20-120 °C[29]. The same results were obtained for MCA4M formulations (1, 3 and 5, Fig. is not shown).
The incorporation of mupirocin in suspension form into the blank formulation which contained MCA15C (formulation 4, Figure3), caused a decrease in the intensity of this melting point peak. This might be due to the mupirocin crystal adsorption process on the surface of MC polymer, thus controlling the crystal growth of that drug [30]. Another simple suggestion for this result maybe because there was not as much mupirocin in the mixed sample as there was in the pure drug sample.

Fig. 3: DSC thermogramof mupirocin powder and MC formulations 2, 4 and 6
The use of organic solvent (tertiary butyl alcohol) to dissolve the drug (mupirocin) in formulation 6 led to production of an amorphous form of mupirocin. This result was concluded due the disappearance of the melting point of the drug [27]as shown in formulation 6, Figure3. This was in agreement with SEM images as shown in fig. 2e. So, the use of co-solvent (tertiary butyl alcohol) caused solublization of mupirocin. Consequently, astrong hydrogen bonding might have resulted in this phase between the water soluble polymers and the drug. This led to entrapping of that drug by co-solvent effect. Subsequently, mupirocin (hydrophobic drug) had a great inhibition of its crystallization[31]. This confirmed the results of dynamic adhesion and water uptake results using the DVS which were obtained due to new physical properties that were completely different from mupirocin suspension containing formulations.
Nuclear magnetic resonance (NMR)
As physical changes were confirmed by the previous studies, NMR was performed on aqueous prepared formulations3 and 4 (MCA15C+mupirocin suspension) and organic prepared formulations 5 and 6 (MCA15C+mupirocin solution) to clarify the hypothesized reasons. NMR spectrum was obtained for all formulations in order to identify any residualof tertiary butyl alcohol in formulations5 and 6. The NMR spectrum of formulation 6 in fig. 4b (tertiary butyl alcohol used as an organic solvent) is similar to that of formulation 4 in fig. 4a. The same result was obtained for aqueous prepared formulation 3 in comparison to organic prepared formulation 5 (fig. is not shown). Therefore, there was no solvent embedded within that formulation since the peak of tertiary butyl alcohol should be at 1.2-1.25 ppm[32]. Then, changes in the tertiary butyl alcohol containing formulations resulted from physical changes in the matrix of the formulation as evident by SEM images.

Fig. 4: NMR spectrum of formulations 4and 6
Mupirocin release
The release profile of mupirocin from different grades and same concentration of MC was studied. Both formulation 3 (MCA4M loaded with mupirocin suspension) and formulation 4 (MCA15C loaded with mupirocin suspension) showed no significant difference in the release rate of mupirocin (f251) as shown in Figure5. The use of 20% of tertiary butyl alcohol as an organic solvent to dissolve the mupirocin in formulations 5 and 6, also gave no significant difference with f299.92 when different grades of MC were used as shown in Fig. 5 The difference in the release rate of mupirocin between aqueous and organic prepared formulations was also studied. There was a significant decrease in the release rate of mupirocin form formulations 5 and 6in comparison to formulations 3 and 4.

Fig. 5: Release profile of mupirocin from aqueous, organic and Bactroban nasal formulations, n=6
It is hypothesized that the preparation of mupirocin containing formulations using organic solvent to dissolve that drug might cause an interaction or complex formation of mupirocin-MC that entrapped the mupirocin. Consequently, a low release rate of mupirocin from that complex was produced.
The result of release rate of 2%w/wmupirocin from the commercial dosage form (Bactroban nasal ointment) was unexpected; the maximum percent release was just 4% after about 125 minutes as shown in Figure5. the reason for that might be due to resistance to drug diffusion by the base ointment [33].
Antibiotic sensitivity test
The results obtained from the antibiotic sensitivity test showed that mupirocin loaded into freeze dried disc formulations inhibited the growth of staphylococcus aureus. For example, the presence of mupirocin in the aqueous prepared formulation 4 inhibited the growth of staphylococcus aureus as shown in Fig.6 The diameter of zone of inhibition was measured for formulations 3-6 and for Bactroban ointments.
Fig. 6: Inhibition zoneof formulation 4, n=3
The use of 20% tertiary butyl alcohol to dissolve mupirocin in formulations 5 and 6, organic prepared formulations, which were also contained MCA4M and MCA 15C respectively showed no significant difference in the diameter of the zone of staphylococcus aureus growth inhibition in comparison with formulations 3 and 4 respectively (aqueous prepared formulations). This probably due to all formulations had sufficient time, 24 hours, to release all mupirocin content.
However the prescribed dose of Bactroban nasal ointment also had enough time (24 hours) to release its mupirocin content, the result obtained from this test was unexpected. The zone of staphylococcus aureus growth inhibition was smaller in comparison with our nasal inserts loaded with 2% mupirocin. There was a significant increase in the diameter of the zone of staphylococcus aureus growth inhibition in all mupirocin containing formulations which we prepared in this study in comparison to Bactroban nasal ointment. The reason for that might be due to elaborate in the drug release from the ointment bases as mentioned in the release section. In addition, low adhesion of this ointment to the mucin-agar plates employed in the adhesion test. This suggests that rapid clearance of ointment from the nose by MCC and the low release of mupirocin from the ointment produced decrease in its antibiotic action to eliminate MRSA. All these factors can explain the reasons of resistance of MRSA to that drug or relapses happened after its applications as reported in many literatures [3, 7].
CONCLUSION
The properties of the freeze dried nasal inserts were measured by using appropriate In vitro testing techniques which can eliminate ineffective formulations and identify the most feasible for future in vivo testing. The dynamic adhesion property of the freeze dried nasal inserts was shown, by the use of mucin/agar plate method, to increase with increasing in the polymer molecular weight and addition of mupirocin dissolved by tertiary butyl alcohol.
The variation in the solubility of the drugs integrated into the polymer matrix affected the drug release profiles of mupirocin. The freeze dried formulations showed agood inhibition of Staphylococcus aureus with the aqueous and organic prepared formulations.
To sum up all results which we have obtained, while drug release of mupirocin solution formulations (organic) was lower than mupirocin suspension containing formulations (aqueous), both formulations5 (MCA4M and Mupirocin solution) and 6 (MCA15C and Mupirocin solution) were promising tobe developed in order to prepare an active dosage formused in prevention of serious infections caused by MRSA because they had the best dynamic adhesion. The problem of lower drug release obtained from these formulations was less relevant, as the dynamic adhesion of these formulations was quite high. Thus, these formulations had enough time to be rehydrated, swell and release mupirocin. So, they achieved the full effect of the drug (mupirocin) on growth inhibition of staphylococcus aureus. This suggests the use of a freeze dried nasal insert dosage system for the treatment of nasal carriage of MRSA shows a great deal of promise, and may offer improved therapy over the current commercial standard, Bactroban nasal ointment. Since these inserts will rehydrate inside the nose to form muco adhesive gels and stick locally to increase the residence time of these formulations. Further works include stability and clinical studies are required to evaluate the accomplishment of this formulations.
CONFLICT OF INTERESTS
Declared None
ACKNOWLEDGMENT
The authors are thankful to the University of Strathclyde/ SIPBS labs to provide all the facilities for this project.
REFERENCES